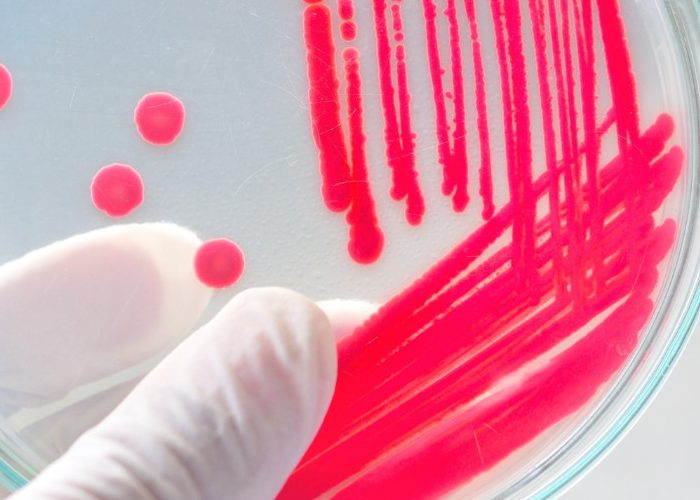
bakterien wundheilung petrischale e1697185142461

Die Zahl ist beachtlich: Rund 90 % der Zellen auf unserer Haut sind Bakterien. Wie im Darm gibt es auch hier „gute“ und „schädliche“ Vertreter, letztere werden vor allem bei flächigen oder tiefen Wunden zum Problem und stören die Wundheilung. Doch umgekehrt zeigen erste Forschungen, dass geeignete nützliche Bakterien einen neuen Therapieansatz bieten können: Wir sprachen mit Univ.-Prof. Dr. med. Ewa Klara Stürmer über das Management von Wunden und darüber, welche Rolle Probiotika in Zukunft spielen könnten.
Ursache von nicht heilenden Wunden
bauchgefühl: Wie viele Wundpatienten gibt es ungefähr jährlich in Deutschland und welche Bakterien sind die häufigsten Verursacher nicht heilender Wunden?
Univ.-Prof. Dr. med. Ewa Klara Stürmer: Das ist schwer zu schätzen, denn Wundpatienten werden in Deutschland von verschiedenen Disziplinen behandelt. Wenn es sich um postoperative Infektionen handelt, dann therapieren natürlich primär die entsprechenden Chirurgen, darüber hinaus Gefäßmediziner, Dermatologen, Allgemeine Chirurgen und Diabetologen. Chronische Wunden sind also keiner Fachdisziplin zugeordnet. Wir wissen aber aus der großen PMV-Studie von 2016, dass es zu jenem Zeitpunkt rund drei Millionen Wundpatienten waren. Davon hatten rund zwei Drittel chronische Wunden. Was die „Hauptverursacher“ von Wundinfektionen angeht, wurde sowohl in nationalen als auch in internationalen Studien mit über 50 % Staphylococcus aureus identifiziert, davon in ca. 9 % als methicillinresistenter Staphylococcus aureus (MRSA). Wobei hier einschränkend gesagt werden muss: Solange der MRSA auf der Wunde bleibt, ist er genauso sensibel gegenüber unseren Antiseptika wie der „normale“ Staphylococcus aureus. Er wird dann zu einem echten Problem, wenn sich aus einer oberflächlichen Wundinfektion eine tiefe Infektion entwickelt und im Körper ausbreitet. Die Auswahl der jetzt notwendigerweise einzusetzenden Antibiotika ist dann wegen der Resistenz des Bakteriums eher beschränkt. Ein weiteres Bakterium, welches häufig chronische Wunden besiedelt, ist mit 30 % der Pseudomonas aeruginosa, was auch auf Enterobakterien zutrifft. Sie alle sind Hauptfeinde einer funktionierenden Wundheilung.

Diabetes und Wundheilung
bauchgefühl: Sind immer größere Verletzungen der Grund für schlecht heilende Wunden oder kann selbst aus einem kleinen Kratzer solch ein Problem resultieren? Und: Warum sind Diabetiker so häufig von Wundheilungsstörungen betroffen?
Univ.-Prof. Dr. med. Ewa Klara Stürmer: So ganz aus dem Nichts entstehen diese Wunden nicht. Bei älteren Patienten mit Durchblutungsstörungen in den Beinen sind aber tatsächlich oft Bagatellverletzungen ursächlich: kleine Stoßwunden bei der Gartenarbeit, eine Risswunde beim Rosenstrauch oder auch aufgekratzte Insektenstiche, welche zur Basis einer chronischen Wunde werden. Bei Diabetikern sind es häufig offene Druckstellen an den Füßen. Da viele Diabetiker eine sogenannte Polyneuropathie entwickeln – was bedeutet, dass die Nerven nicht mehr entsprechende Schmerzsignale senden, wenn der Schuh drückt –, laufen sie sich Blasen insbesondere an der Fußsohle oder an Knochenvorsprüngen, die dann aufbrechen und in chronische Wunden übergehen.
Fortschritte in der Wundversorgung
bauchgefühl: Als Laie bekommt man manchmal den Eindruck, dass sich bei der Versorgung von Wunden nicht so viel getan hat wie in anderen medizinischen Feldern. Stimmt das, oder wie sieht hier die wissenschaftliche Wirklichkeit aus?
Univ.-Prof. Dr. med. Ewa Klara Stürmer: Ein „klares Jein“. Wir haben in den letzten Jahren, wo sich alles auf COVID-19 fokussiert hatte, keine richtigen Innovationen in der Wundtherapie festgestellt, obwohl wir durch die Angst der Wundpatienten, Ambulanzen und Krankenhäuser zu besuchen, und durch Versorgungslücken bei den Pflegediensten deutlich mehr und deutlich schlimmere Wunden gesehen haben. Die sogenannte „Moderne Wundtherapie“ gibt es mittlerweile seit 40 Jahren. Sie war durch die Einführung der feuchten Wundtherapie ein Meilenstein für die Wundheilung. Davor hatte man gedacht, Wunden müssten austrocknen. Auf akute Wunden mag das auch weiterhin zutreffen, aber die Einführung dieser neuen, feuchten Therapiephilosophie war ein Segen für die chronischen Wunden. Auch wenn es in letzter Zeit diesbezüglich keine echten Innovationen gab, so sind die Wundmaterialien immer besser und effektiver geworden. Sie kleben weniger stark und sind dünner. Erwähnenswert ist außerdem die Entwicklung der Unterdrucktherapie, bei der die Wunde mit einem Schwamm und einer Folie bedeckt und unter Anlage von Unterdruck feucht und sauber gehalten wird, was die Wundheilung anregt. Weiters hat uns die Medizinprodukteindustrie inzwischen ein breites Spektrum effektiver antimikrobieller Substanzen und Lösungen zur Verfügung gestellt, die uns dabei helfen, Wundinfektionen von außen zu kontrollieren. Aber über Rocket Science oder Meilensteine konnten wir uns meines Erachtens in den letzten 15 Jahren leider nicht freuen.
Antibiotika und Wundheilungsstörung
bauchgefühl: Antibiotika waren der größte Segen der Menschheit, die zunehmenden Resistenzen gegen diese Medikamente werden immer mehr zu einem Problem. Ist das auch in Hinblick auf die Wundversorgung ein Thema?
Univ.-Prof. Dr. med. Ewa Klara Stürmer: Jede chronische Wunde ist von verschiedensten Bakterienspezies besiedelt. Wenn man das mit PCR-Diagnostik analysiert, kommen wir auf bis zu 70 verschiedene Bakterien. Die muss ich aber nicht zwangsläufig mit Antibiotika bekämpfen: Bei einem bakterienpositiven Abstrich schaue ich mir den Patienten und die Wunde an. Jeder Arzt sollte zuerst eruieren, ob nur eine Besiedelung der Wunde vorliegt, die den Patienten nicht krank macht, oder ob es sich um eine lokale Infektion bzw. sogar um eine systemische Infektion handelt. Denn Patienten mit chronischen Wunden zeigen immer wieder ein Aufflammen von Infektionen. Unreflektiert würde jedes Mal ein Antibiotikum verordnet werden. Den typischen Wundpatienten beträfe das zwei- bis dreimal pro Jahr. Dadurch ist die Entwicklung von resistenten Bakterien vorprogrammiert.
Natürlich sind Antibiotika ein Segen, aber stets zurückhaltend bei Patienten mit chronischen Wunden einzusetzen. Deswegen suchen wir nach Alternativen, da trotz aller Umsicht die Zahl der resistenten Bakterien steigt.
Risiko einer Wundinfektion im Krankenhaus
bauchgefühl: Wie hoch ist denn das Risiko einer Wundinfektion im Krankenhaus? Gibt es bestimmte Patientengruppen, die besonders gefährdet sind?
Univ.-Prof. Dr. med. Ewa Klara Stürmer: Die Älteren – auch deshalb, weil die Stoffwechselprozesse mit zunehmendem Alter langsamer werden. Aber es sind tatsächlich gehäuft Patienten mit Diabetes und die Adipösen, außerdem Patienten, bei denen beides zusammenkommt, basierend auf dem sogenannten Metabolischen Syndrom. Jene leiden also an komplexen Stoffwechselstörungen, die auch die Wundheilung erschweren. Hinzu kommt natürlich, dass bei diesen Patienten das Mikrobiom eine große Rolle bei der verzögerten Wundheilung spielt, weil sie bekanntlich eine ganz andere Zusammensetzung des Haut- und Darmmikrobioms aufweisen und pathogene Keime deswegen ein leichtes Spiel haben.
bauchgefühl: Diabetes Typ 2 ist ja mittlerweile eine Volkskrankheit, und Diabetiker haben oft mit Wundheilungsstörungen zu kämpfen. Wie lange kann es dauern, bis bei einem Diabetiker eine offene Wunde heilt, und warum ist das so?
Diabetische Wunden heilen sehr, sehr langsam. Sie heilen quasi genauso langsam wie bei Patienten mit arteriellen Durchblutungsstörungen, weil sie einfach durch das Metabolische Syndrom eine schlechtere Immunabwehr und eine schlechtere Mikrodurchblutung haben. Durch die Grunderkrankung ist die Infektabwehr teilweise so beeinträchtigt, dass man durch engmaschige Verbandswechsel dem Körper helfen muss, die Erreger von den Wunden zu entfernen. Aber das allein ist nicht immer ausreichend und im Alltag für Patient und Wundversorgende auch nicht immer praktikabel. So entstand unter anderem als neue Idee, das Mikrobiom in den Prozess der Wundheilung einzubeziehen. Sein Einfluss auf die Darmgesundheit ist ja hinlänglich bekannt. Und so unterschiedlich sind Darm, Schleimhäute und Haut gar nicht aufgebaut, alle sind von Bakterien besiedelt und die Mechanismen auf histologischer und zellulärer Ebene ähnlich. Die Forschung rund um die Darmbarriere ist ja schon sehr weit. Klarerweise hat man sich auf die orale Einnahme der Probiotika konzentriert. Wer wendet schon Probiotika auf der Haut an? Hier kann die Forschung Brücken schlagen, es ist naheliegend, dass die Mechanismen des Hautmikrobioms sehr ähnlich verlaufen wie jene im Darm.

Welche Rolle spielen Probiotika in der Wundheilung?
bauchgefühl: Welche Rolle können denn Probiotika bei der Heilung von Wunden spielen? Was ist der aktuelle Stand der Wissenschaft – könnten probiotische Bakterien eventuell sogar die Wundheilung beschleunigen?
Univ.-Prof. Dr. med. Ewa Klara Stürmer: Wir schließen gerade eine Pilotstudie zur Wirkung eines speziellen Probiotikums auf die Wundheilung ab und von einem Trend kann ich gern schon berichten. Wir haben dafür ein Multispezies-Probiotikum gewählt, das speziell für Diabetiker und das Metabolische Syndrom entwickelt wurde, da unsere Studienpatienten allesamt Diabetiker waren. Eines der wesentlichen Ergebnisse war, dass eine sechsmonatige Einnahme des Probiotikums zu einer Veränderung des Haut- und Wundmikrobioms von pathogen zu weniger pathogen führte. Das ist insofern beeindruckend, als die Patienten die Probiotika morgens in einem Glas Wasser – also oral – zu sich genommen haben. Es zeigte sich, dass probiotische Bakterien über die Mundschleimhaut und den Darm den Weg auf die Haut und schlussendlich auf die Wunde gefunden haben. Auf jeden Fall ist es beeindruckend, dass eine orale Einnahme von Probiotika sich positiv auf das Hautmikrobiom auswirkt. Wir werden dazu hoffentlich bald eine größere Studie durchführen und ich bin sehr zuversichtlich, dass sich die besagten Auswirkungen auch in dieser zeigen werden. In der Pilotstudie haben wir zudem gesehen, dass sich bei Diabetikern die Parodontitis signifikant verbessert hat, und zwar bei fast allen Patienten. Das war beeindruckend! Wenn Sie bedenken, wie im Vergleich eine regelhafte Parodontitis-Therapie verläuft – langwierig, mit vielen Zahnarztbesuchen, Mundspülungen und schmerzhaften Reinigungen –, so ist eine sechsmonatige Probiotika-Einnahme ein Leichtes, die Zahngesundheit deutlich zu verbessern. Das heißt, die Probiotika haben definitiv einen Effekt auf Haut und Schleimhaut. Inwiefern sie vielleicht auch einmal Antibiotika werden ersetzen können, lässt sich schwer sagen. Wenn ich in die Zukunft schaue, werden Probiotika meines Erachtens ein weiteres Tool in der Therapie chronischer Wunden sein. Gerade bei schwelenden Infektionen werden Probiotika einen Stellenwert haben.
bauchgefühl: Wie sind Sie auf die Idee gekommen, dass Probiotika in der Wundheilung eine Rolle spielen könnten?
Univ.-Prof. Dr. med. Ewa Klara Stürmer: Meine Arbeitsgruppe hat vor rund drei Jahren eine Studie publiziert, in der wir im Labor die Wirkung von probiotischen Bakterien auf humane Krankheitserreger im bakteriellen Biofilm untersucht haben. Das heißt, wir haben aus Blutplasma, Immunzellen und Bakterien einen Biofilm hergestellt, wie er auf chronischen Wunden zu finden ist. Damit prüften wir, ob verschiedene Probiotika diesen Biofilm und die Bakterien darin töten können. Zu meiner Überraschung konnte der Lactobacillus plantarum einen der aggressivsten Hautkeime, den Pseudomonas aeruginosa, töten und den Staphylococcus aureus in seinem Wachstum hemmen. Diese Beobachtungen erfolgten zwar erst einmal nur im experimentellen Setting, aber in humanem Milieu und somit schon nah am realen menschlichen Biofilm. Bei den Untersuchungen haben wir das große Potenzial von Probiotika entdeckt, auch wenn es bei chronischen Wunden noch viel zu erforschen gibt, insbesondere welche „guten“ Keime wir benötigen: Den Lactobacillus plantarum können wir aber sicherlich sehr gut gebrauchen.
Er macht insbesondere in der Wunde den pH-Wert ein bisschen saurer, was den typischen Wundinfektionserregern gar nicht gefällt. Es ist ein bisschen so wie David und Goliath: Denn wir haben es bei der Problematik der Wundinfektionen mit hochaggressiven Keimen zu tun, denen jetzt viele sympathische kleine Bakterien gegenüberstehen, die über sich hinauswachsen und vielleicht sogar siegen können.























































